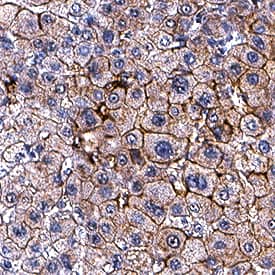
Apolipoprotein B/ApoB antibody in Human Liver by Immunohistochemistry (IHC-P).

Human Apolipoprotein B/ApoB Antibody
R&D Systems, part of Bio-Techne | Catalog # MAB41242


Conjugate
Catalog #
Key Product Details
Species Reactivity
Validated:
Human
Cited:
Human
Applications
Validated:
Immunohistochemistry, Western Blot, Simple Western
Cited:
Immunoblotting, ELISA Detection
Label
Unconjugated
Antibody Source
Monoclonal Mouse IgG1 Clone # 1008037
Product Specifications
Immunogen
E. coli-derived recombinant human Apolipoprotein B/ApoB
Ile3374-Val3600
Accession # P04114
Ile3374-Val3600
Accession # P04114
Specificity
Detects human Apolipoprotein B/ApoB in direct ELISAs.
Clonality
Monoclonal
Host
Mouse
Isotype
IgG1
Scientific Data Images for Human Apolipoprotein B/ApoB Antibody
Detection of Human Apolipoprotein B/ApoB by Western Blot.
Western blot shows lysates of human plasma. PVDF membrane was probed with 1 µg/mL of Mouse Anti-Human Apolipoprotein B/ApoB Monoclonal Antibody (Catalog # MAB41242) followed by HRP-conjugated Anti-Mouse IgG Secondary Antibody (Catalog # HAF018). A specific band was detected for Apolipoprotein B/ApoB at approximately 500 kDa (as indicated). This experiment was conducted under reducing conditions and using Immunoblot Buffer Group 1.Apolipoprotein B/ApoB in Human Liver.
Apolipoprotein B/ApoB was detected in immersion fixed paraffin-embedded sections of human liver using Mouse Anti-Human Apolipoprotein B/ApoB Monoclonal Antibody (Catalog # MAB41242) at 5 µg/mL for 1 hour at room temperature followed by incubation with the Anti-Mouse IgG VisUCyte™ HRP Polymer Antibody (Catalog # VC001). Before incubation with the primary antibody, tissue was subjected to heat-induced epitope retrieval using Antigen Retrieval Reagent-Basic (Catalog # CTS013). Tissue was stained using DAB (brown) and counterstained with hematoxylin (blue). Specific staining was localized to plasma membrane in hepatocytes. View our protocol for IHC Staining with VisUCyte HRP Polymer Detection Reagents.Detection of Human Apolipoprotein B/ApoB by Simple WesternTM.
Simple Western shows lysates of human plasma, loaded at 1:50. A specific band was detected for Apolipoprotein B/ApoB at approximately 315 kDa (as indicated) using 5 µg/mL of Mouse Anti-Human Apolipoprotein B/ApoB Monoclonal Antibody (Catalog # MAB41242). This experiment was conducted under reducing conditions and using the 66-440kDa separation system.Applications for Human Apolipoprotein B/ApoB Antibody
Application
Recommended Usage
Immunohistochemistry
5-25 µg/mL
Sample: Immerson fixed paraffin-embedded sections of human liver
Sample: Immerson fixed paraffin-embedded sections of human liver
Simple Western
5 µg/mL
Sample: Human Plasma
Sample: Human Plasma
Western Blot
1 µg/mL
Sample: Human Plasma
Sample: Human Plasma
Formulation, Preparation, and Storage
Purification
Protein A or G purified from hybridoma culture supernatant
Reconstitution
Reconstitute at 0.5 mg/mL in sterile PBS. For liquid material, refer to CoA for concentration.
Formulation
Lyophilized from a 0.2 μm filtered solution in PBS with Trehalose. *Small pack size (SP) is supplied either lyophilized or as a 0.2 µm filtered solution in PBS.
Shipping
Lyophilized product is shipped at ambient temperature. Liquid small pack size (-SP) is shipped with polar packs. Upon receipt, store immediately at the temperature recommended below.
Stability & Storage
Use a manual defrost freezer and avoid repeated freeze-thaw cycles.
- 12 months from date of receipt, -20 to -70 °C as supplied.
- 1 month, 2 to 8 °C under sterile conditions after reconstitution.
- 6 months, -20 to -70 °C under sterile conditions after reconstitution.
Background: Apolipoprotein B/ApoB
Human ApoB (Apolipoprotein B-100) is a 550 kDa, secreted, palmitoylated glycoprotein that is part of LDL and VLDL particles. It is made by liver and is 4536 amino acids (aa) in length. It binds LDL to the ApoB/E receptor. Multiple forms of ApoB-100 exist; ApoB-25, 26, 29, 37, 39, 48, and 74. The numbers reflect each molecule’s predicted MW as a percentage of ApoB-100 (512 kDa). Amino acids 1206-1414 of the precursor were used for immunization. Based on likelihood of secretion, this antibody may recognize B26 (1297 aa), B37 (1728 aa), B39 (1799 aa), and B48 (2152 aa). Over the immunization polypeptide range, human ApoB-100 is 80% and 82% aa identical to mouse and dog ApoB-100, respectively.
Alternate Names
APOB, ApoB-100, ApoB-48, FLDB, LDLCQ4
Gene Symbol
APOB
UniProt
Additional Apolipoprotein B/ApoB Products
Product Documents for Human Apolipoprotein B/ApoB Antibody
Product Specific Notices for Human Apolipoprotein B/ApoB Antibody
For research use only
Loading...
Loading...
Loading...
Loading...